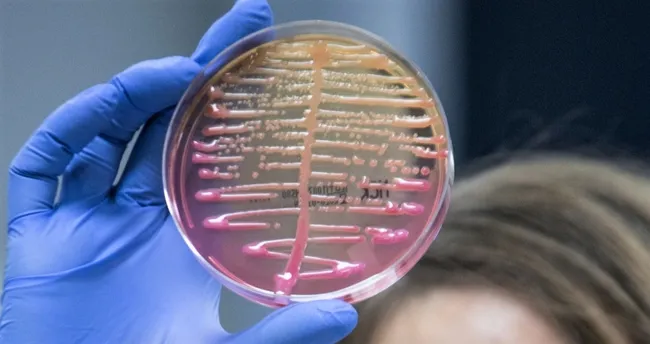
“Klebsiella pneumoniae” bakterisi antibiyotiklere karşı direnç kazanacak

Kan, yara, idrar yolu enfeksiyonları ile menenjit ve zatürre gibi hastalıklara neden olan “Klebsiella pneumoniae” bakterisinin dirençli türlerinin, 5 yıl sonra antibiyotiklere tamamen dirençli hale geleceği…Devamı için tıklayınız

Influencer Reklam Ajansı Seçerken Neden Doğru Ajans Hayati Öneme Sahiptir?

Bulaşıcı değil ama salgın gibi yayılıyor!

Dr. Fedai, aşırı sıcaklara karşı kalp hastalarını uyardı
5 sokak köpeği 53 yaşındaki kadına dehşeti yaşattı: Bir çare bulunsun
Sağlık müdürü Nacar: ASM’ler vatandaşlarımız için önemli

Göz renginiz hastalığınızı belirliyor
